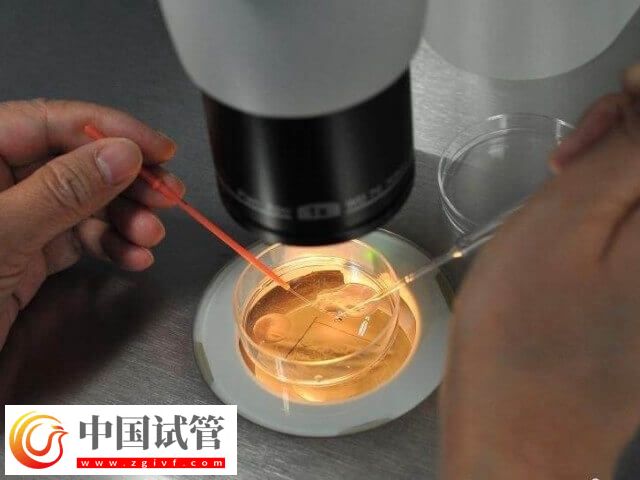
胚胎着床失败是什么情况(图1)

胚胎着床失败通常是由多种因素引起的,一般可能是胚胎质量差,或者存在染色体异常,可能会导致着床失败。同时子宫内膜的厚度和状态对胚胎着床非常关键,如果患者内膜过薄或存在炎症、感染等问题,都可能影响胚胎的着床,从而导致胚胎着床失败。
胚胎着床失败的原因
做试管婴儿的目的是为了帮助不孕人群实现生育,但试管婴儿技术只是一种辅助生殖技术手段,并不能保证一定怀上,所以也可能面临试管治疗失败的情况。如果大家想要了解,胚胎着床失败是什么情况,可以参考下列内容:
1、胚胎质量
对于多次移植卵裂期胚胎不着床的情况,可能是胚胎质量差,或是存在染色体异常等情况,如果总是出现移植失败或着床失败,可以考虑养囊来筛选有发育潜力的胚胎。
2、子宫内膜
子宫内膜是胚胎着床的部位,所以正常情况下都是要求子宫内膜厚度在8-12mm之间才适合移植。如果内膜不在这个范围,可能会影响移植的成功率,同时如果有过流产史,或是内膜受过基底层损伤等情况,也会影响胚胎的着床情况。
3、免疫和内分泌因素
试管移植后出现失败,可能是母体的免疫状态异常,如存在自身免疫性疾病或免疫细胞对胚胎的攻击,会影响胚胎的着床和发育。此外,内分泌失调,特别是黄体功能不全,也会影响胚胎着床。
4、其他因素
在试管婴儿移植之后,如果患者存在凝血状态异常,比如血液中存在高凝状态可能导致血流不畅,影响子宫内膜的营养供给,从而影响着床。





